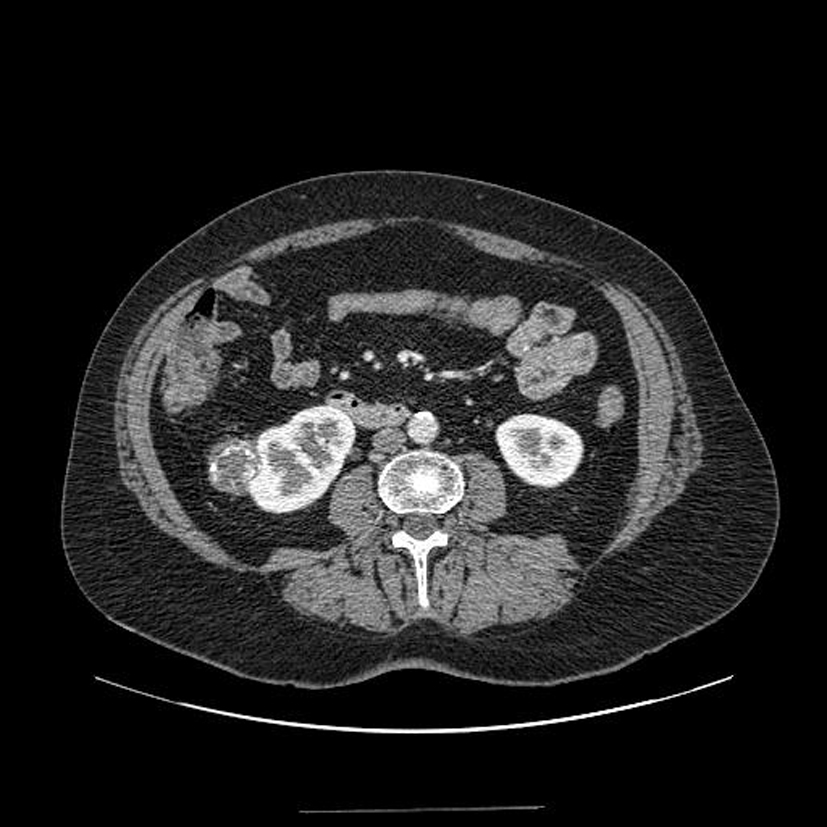

Qu’est-ce que c’est?

Hydrocèle. Ca doit être indolore, juste gênant; regarder si c’est transilluminable
Qu’est-ce que c’est ? De quelle pathologie génito-scrotale est-ce une complication? Quelles sont les autres?

Paraphimosis. C’est l’une des complications du phimosis avec la balanoposthite, la formation d’une poche préputiale qui se remplit d’urine à chaque miction et de la déviation du jet mictionnel
Qu’est-ce que c’est ? jusqu’à quel âge est-ce physiologique?

Phimosis. C’est physiologique chez l’enfant, doit disparaître avant 2 ans mai son peut considérer que c’est physiologique jusqu’à 4 ans. ttt à partir de 2 ans, d’abord médical puis chirurgical si échec
Qu’est-ce que c’est?

Torsion du cordon spermatique! On avait 6h pour l’exploration chirurgicale
Voici la débitmétrie d’un bilan urodynamique, comment est l’aspect de la courbe?

Débitmétrie normale, courbe en cloche, petit résidu post-mictionnel
Comment est cette débitmétrie?

débitmétrie normale, courbe en dôme, pas de résidu post-mictionnel
Voici des images de débitmétrie, comment est la courbe de droite?

la débitmétrie de droite correspond à une obstruction car courbe plate
Bilan de dysurie, on réalise une débitmétrie. Quel est l’aspect de la courbe?

Courbe de débitmétrie pathologique avec nombreuses poussées abdominales
Voici une échographie vésicale réalisée au décours d’un bilan de dysurie, que voit-on?

Vessie de lutte (grosse) avec nombreux diverticules
Fibroscopie vésicale réalisée au cours d’un bilan de troubles mictionnels, que voit-on?

Vessie de lutte avec diverticules et colonnes musculaires
Quel est cet examen? Que voit-on?

Urétrocystographie rétrograde et mictionnelle = vessie de lutte car aspect en arbre de Noël
Diagnostic? Quelle maladie héréditaire peut favoriser ce genre de lésion surtout si bilatérales?

Angiomyolipome du rein gauche reconnaissable à sa composante graisseuse.
La Sclérose Tubéreuse de Bourneville donne des agniomyolipomes bilatéraux
Que voit-on sur cet examen?

C’est un ASP. On voit des images de calculs vésicaux radio-opaques
Diagnostic?

Courbure latérale gauche et dorsale acquise dans le cadre d’une maladie de Lapeyronie.
Diagnostic?

Kyste du rein droit. Pas d’éléments atypiques (pas de cloison, de calcifications, de paroi épaissie, de réhaussement par le PDC, de végétations intra-kystiques)
Que voit-on sur cette échographie?

kyste du rein= d’allure simple car lésion anéchogène avec renforcement postérieur non vasculaire sans végétations et à parois fines. (! Bosniak= définition scannographique!)
Diagnostic?
Petite tumeur rénale droite trouvée de manière fortuite sur un scanner
Diagnostic?

Tumeur rénale droite avec adénopathies au niveau du pédicule rénal
Diagnostic?

Tumeur rénale droite avec thrombus de la veine cave inférieure
Diagnostic?

Tumeur rénale droite avec thrombus de la veine rénale
Diagnostic? Quelle maladie héréditaire peut être en cause?

Tumeurs rénales bilatérales; possible syndrome de Von Hippel Lindau
Diagnostic?

volumineuse tumeur rénale droite


